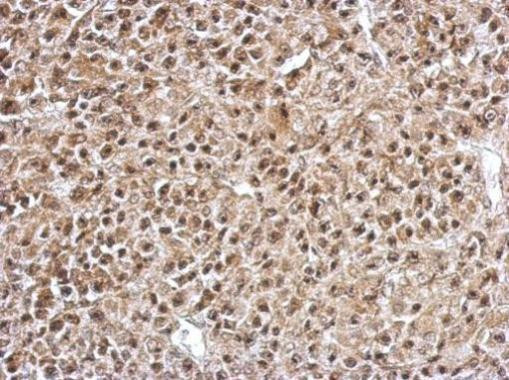
FOXO4 Antibody in Immunohistochemistry (Paraffin) (IHC (P))

Search
Invitrogen
FOXO4 Polyclonal Antibody
{{$productOrderCtrl.translations['antibody.pdp.commerceCard.promotion.promotions']}}
{{$productOrderCtrl.translations['antibody.pdp.commerceCard.promotion.viewpromo']}}
{{$productOrderCtrl.translations['antibody.pdp.commerceCard.promotion.promocode']}}: {{promo.promoCode}} {{promo.promoTitle}} {{promo.promoDescription}}. {{$productOrderCtrl.translations['antibody.pdp.commerceCard.promotion.learnmore']}}
产品信息
PA5-28927
宿主/亚型
分类
类型
抗原
偶联物
形式
浓度
规格
保存条件
运输条件
RRID
产品详细信息
Recommended positive controls: 293T, A431, H1299, HeLa, HepG2, Molt-4, Raji.
Predicted reactivity: Mouse (85%), Rat (84%), Bovine (88%).
Store product as a concentrated solution. Centrifuge briefly prior to opening the vial.
靶标信息
FOXO4 (Forkhead box O4) is encoded by the FOXO4 gene located on the X chromosome. It is also known as AFX1 or MLLT7 (Myeloid/Lymphoid or Mixed-Lineage Leukemia (Trithorax Homolog, Translocated To, 7) and is a member of the O class of forkhead/ winged helix family of transcription factors along with FOXO1, FOXO3 and FOXO6. FOXO4 is abundantly expressed in skeletal muscle and adipose tissue. FOXO4 binds to the Insulin Responsive Element (IRE) and activates downstream targets of Insulin/IGF1 signaling such as IGFBP1. However, the activation of another downstream target of the Insulin/IGF1 pathway, Akt, leads to phosphorylation of FOXO4 on specific Ser/Thr residues. This phosphorylation mediates binding of FOXO4 to 14-3-3 and eventual exit of FOXO4 from the nucleus.
⚠WARNING: This product can expose you to chemicals including mercury, which is known to the State of California to cause birth defects or other reproductive harm. For more information go to www.P65Warnings.ca.gov.
仅用于科研。不用于诊断过程。未经明确授权不得转售。